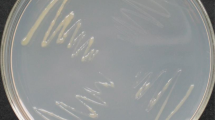

Abstract
The transcriptional regulator HrpB activates the entire hrp regulon in the plant pathogen Ralstonia solanacearum. Through a complex multigene regulatory cascade PrhA–PrhR/PrhI–PrhJ–HrpG, expression of hrpB is induced in a hrp-inducing, nutrient-poor medium and in response to contact between the bacterium and plant cell. In this study, we analyzed the expression levels of these regulatory genes and hrpB using lacZ reporter strains grown in three different conditions: in a nutrient-rich or nutrient-poor medium and co-cultivated with Arabidopsis thaliana seedlings. We found that prhA and prhIR were expressed constitutively. Expression of prhJ and hrpG was PrhA-dependent in all three conditions. Despite the high level of hrpG expression in all cases, hrpB was induced only when the bacteria were co-cultivated with A. thaliana seedlings or grown in nutrient-poor medium. A mutation in the predicted phosphorylation site of hrpG greatly reduced the function of HrpG. From these results, we conclude that the prhA-dependent regulatory cascade controls the expression of hrpG, and a new cascade, which is induced by a signal from plant cells, activates HrpG by phosphorylation. Only when both signal cascades are effective is full expression of hrpB induced. We speculate that the metabolic status of the bacteria in the nutrient-poor medium also contributes to the second cascade.
Similar content being viewed by others
Avoid common mistakes on your manuscript.
Introduction
The type III secretion system (TTSS) of Gram-negative plant and animal pathogens translocates effector proteins into host cells (Galán and Collmer 1999; Hueck 1998). In plant pathogenic bacteria, the TTSS is encoded by a cluster of approximately 20 hrp genes (Hueck 1998) that are organized into several operons (Arnold et al. 2003). TTSS-defective mutants of the soil-borne pathogen Ralstonia solanacearum, like other Gram-negative plant pathogens, are unable to cause disease on susceptible host plants or to elicit the hypersensitive reaction (HR) in resistant hosts. Mutant cells are unable to colonize the intercellular spaces of host plants (Hueck 1998; Kanda et al. 2003a).
TTSS construction in R. solanacearum is strongly influenced by the growth environment (Arlat et al. 1992; Genin et al. 1992; Mukaihara et al. 2004). The hrp regulon is repressed in nutrient-rich media. Concomitantly, a low-level expression of hrpB, which encodes an AraC-type transcriptional activator of the entire hrp regulon, is observed. Nutrient-poor conditions, which may mimic conditions in the intracellular spaces of plants, induce 20-fold expression of the hrp regulon. Plant signal(s) enhance the expression of the operons belonging to the hrp regulon 10- to 20-fold more than do nutrient-poor conditions (Marenda et al. 1998). The expression of hrpB is activated through a complex multigene regulatory cascade PrhA–PrhR/PrhI–PrhJ–HrpG (Fig. 1) initiated during bacterium-plant cell contact (Aldon et al. 2000; Brito et al. 1999, 2002; Cunnac et al. 2004). Plant cell signals are presumed to be recognized by PrhA, which is located on the outer membrane of the bacterial cell.
A LysR-type transcriptional activator PhcA was originally identified as a positive regulator of the production of a major virulence factor, extracellular polysaccharide (EPS) (Brumbley et al. 1993). In addition to EPS, PhcA coordinates several virulence factors, positively regulating β-1,4-endoglucanase and pectin methylesterase and negatively regulating polygalacturonases and motility (Schell 2000). The levels of active PhcA are sensitive to the density of the bacterial cells (Clough et al. 1997). PhcA activity starts to increase at a cell density of 107 CFU/ml and reaches its maximum at 5 × 108 CFU/ml. Recently, PhcA was demonstrated to negatively regulate TTSS expression (Genin et al. 2005). A phcA mutation dramatically increases hrpB and hrp regulon expression even in nutrient-rich medium.
HrpG, a two-component response regulator, is the key component of the regulatory cascade and directly controls hrpB expression (Brito et al. 1999). HrpG has been shown to integrate three major signals: physical contact with the plant host (Aldon et al. 2000), the bacterial metabolic status related to growth conditions (Brito et al. 1999), and a PhcA-dependent quorum sensing signal (Genin et al. 2005). How these three signals interact with each other in different environments to control HrpG activity has not yet been completely elucidated. To address this question, we investigated the expression levels of five genes (prhA, prhI, prhR, prhJ, and hrpG) in the complex multigene regulatory cascade (Fig. 1) in different growth conditions. We found that all five genes were expressed at high levels in all culture conditions tested. We also found that phosphorylation of HrpG, activated by plant signal(s), was necessary for the induction of hrpB expression.
Materials and methods
Bacterial strains and culture conditions
Escherichia coli and R. solanacearum strains used are listed in Table 1. E. coli was grown in LB medium at 37°C, and R. solanacearum was grown at 28°C in rich B medium (Boucher et al. 1985), hydroponic plant culture medium with 2% sucrose (Fujiwara et al. 1992), or was co-cultivated with A. thaliana. Seedlings of A. thaliana cv. Landsberg grown aseptically for 10 days on a plant agar medium (Fujiwara et al. 1992) were mixed with R. solanacearum cells in liquid plant medium with 2% sucrose and incubated at 25°C with rotation and a 16-h day/8-h night cycle.
Reporter strain construction
Plasmid ppop containing popA, popB, and popC (Kanda et al. 2003b) was digested with EcoRI and SphI and cloned into pK18mobsacB (Schäfer et al. 1994) to construct ppop2. A 6.3-kb BamHI-digested promoterless lacZYA fragment from pUC–lacZYA (Mukaihara et al. 2004) was inserted into ppop2 to generate ppop3. The lacZYA fragment was inserted into position 321 of the 1017-bp popA gene. This plasmid was used to construct a popA–lacZYA fusion strain in wild-type strain OE1-1 of R. solanacearum (Kanda et al. 2003a) by homologous recombination.
A hrpB gene fragment was amplified from chromosomal DNA of OE1-1 by PCR with primers hrpBA1 and hrpBB1 (Table 2) and cloned into pBluescript KS(+) to construct phrpB11. The lacZYA fragment was inserted into phrpB11 digested with BglII to make phrpB16. The BamHI–HindIII fragment of phrpB16 was subcloned into pK18mobsacB to generate phrpB18 for hrpB–lacZYA fusion strain construction. The lacZYA was inserted into position 878 of the 1434-bp hrpB gene.
A 2-kb DNA fragment containing both hrpG and prhJ was amplified with primers prhRA1 and hpaBB1 and cloned into pUC119 to generate pUChrpG2. The BamHI–HindIII fragment of pUChrpG2 was recloned into pK18mobsacB to make phrpG10. The lacZYA fragment was inserted into phrpG10 digested with SalI or SalI/XhoI to make phrpG2 for hrpG–lacZYA fusion strain construction and pprhJ2 for prhJ–lacZYA construction. The lacZYA fragment was inserted into position 451 of the 741-bp hrpG gene and position 226 of the 525-bp prhJ gene.
A 2-kb DNA fragment containing prhI and prhR was amplified with primers prhIA1 and prhRB1 and cloned into pGEM-3Zf(+) (Promega, Madison, WI, USA) to generate pprhIR2. The KpnI-digested lacZYA fragment was inserted into pprhIR2 to make pprhIR4. The EcoRI–SphI fragment of pprhIR4 was cloned into pK18mobsacB to generate pprhIR5 for prhIR–lacZYA fusion strain construction. The lacZYA fragment was inserted at 6 bp upstream from the start codon of the 510-bp prhI gene.
A 2.8-kb DNA fragment containing prhA was amplified with primers prhORFxb and popAB10 and cloned into pK18mobsacB to generate pprhA1. After digestion with SphI, the linearized plasmid was blunt-ended with T4 DNA polymerase. The SmaI-digested lacZYA fragment was inserted into the linearized, blunt-ended plasmid to make pprhA2 for prhA–lacZYA fusion strain construction. The lacZYA fragment was inserted into position 477 of the 2313-bp prhA gene.
All the pK18mobsacB-based plasmids were transferred to wild-type OE1-1 through E. coli S17-1 (Simon et al. 1983), and the lacZYA reporter strains were constructed by homologous recombination.
Construction of deletion strains
The 2.8-kb EcoRI–HindIII fragment of pUC118–hrpAC containing hrpA and hrpC (Kanda et al. 2003a) was re-cloned into the same sites of pK18mobsacB to construct phpAC53 for hrpB deletion.
Two DNA fragments flanking the hrpG-coding sequence were amplified with primers prhJA1 and hrpGA3 for the 3′-end region and hrpYA2 and hrpGB3 for the 5′-end region. Both 0.7- and 1.2-kb fragments were mixed and subjected to a second PCR with primers prhJA1 and hrpYA2. The resulting 1.8-kb fragment was cloned into TA vector p3T (MOBiTec, Goettingen, Germany) and recloned into pK18mobsacB to generate pK18dhrpG4.
Two DNA fragments flanking the prhA-coding sequence were amplified with primers prhAA6 and prhAB3 for the 5′-end region and primers prhAB4 and prhAA7 for the 3′-end region. Both PCR products were TA-cloned to make p3TprhA6.3 and p3TprhA7.1, respectively. The EcoRI–BamHI fragment of p3TprhA6.3 and the BamHI–HindIII fragment of p3TprhA7.1 were cloned into pK18mobsacB pre-digested with EcoRI–HindIII by three-way ligation to generate pprhA3.
All pK18mobsacB-based plasmids were used to construct deletion mutants using homologous recombination. The entire gene region of hrpB, hrpG, or prhA was deleted.
Construction of strains with a point mutation in the hrpG gene
Both the 5′ and 3′ halves of hrpG were amplified with primers RV-M and hrpGDN1 or primers M13-47 and hrpGDN2, respectively, using pUChrpG2 as a template. The two PCR products were mixed and subjected to a second PCR with primers M13-47 and RV-M. The final product was digested with SalI and HindIII and cloned into pK18mobsacB to make phrpG10DN, which was used for homologous recombination.
Measurement of β-galactosidase activity
The β-galactosidase assay was performed as described by Miller (1992), with some modifications. When the cell density was low, R. solanacearum cells were collected by centrifugation and concentrated in distilled water. Values are expressed as the means of at least three independent experiments.
Virulence assays
The virulence of R. solanacearum strains was measured using an infiltration method as described by Kanda et al. (2003a). Fully expanded leaves of 4-week-old tobacco plants (Nicotiana benthamiana) were infiltrated with 50 μl of the bacterial suspension at 108 cells/ml using a 1-ml syringe without needle. Each assay was repeated in three successive trials.
Results
hrp regulon induction
The hrp regulon contains at least six operons in the hrp locus, and five of these six operons are controlled by HrpB in R. solanacearum (Cunnac et al. 2004). A popA operon, which has three genes, popA, popB, and popC, belongs to the hrp regulon (Arlat et al. 1994). We constructed a popA–lacZYA reporter strain RK5050 and used it to monitor hrp regulon expression in this study because popABC is not involved in the pathogenicity of R. solanacearum (Arlat et al. 1994; Kanda et al. 2003b). As reported previously (Cunnac et al. 2004; Van Gijsegem et al. 1995), the popA operon was not expressed in nutrient-rich B medium (Table 3). We used a plant medium with 2% sucrose (sucrose medium) as the nutrient-poor culture condition, instead of the hrp-inducing minimal medium with glutamate (MMG; Boucher et al. 1985) because the expression level of the popA operon was higher in sucrose medium than in MMG (data not shown). The expression level of the popA operon in nutrient-poor medium was 10 times higher than that in nutrient-rich medium (Table 3). When RK5050 was mixed with aseptically grown A. thaliana seedlings and incubated in sucrose medium, popA expression was 10 times higher than in the nutrient-poor condition (Table 3). Co-cultivation of RK5050 cells with seedlings of the host plant tomato Solanum lycopersicum cv. Moneymaker induced less popA expression than did co-cultivation with A. thaliana (data not shown). The induction was completely abolished in the hrpB mutant RK5051, indicating that the hrp regulon induction in nutrient-poor medium and when co-cultivated with A. thaliana seedlings were HrpB-dependent. We therefore opted to use the B medium, sucrose medium, and co-cultivation with A. thaliana seedlings as the three culture conditions for hrp regulon expression for this study.
Expression of genes in a complex regulatory cascade under different culture conditions
A six-gene regulatory cascade has been proposed to regulate hrpB expression (Fig. 1) (Brito et al. 2002). We constructed five reporter strains to monitor the expression of these genes. None of the reporter strains were pathogenic to the host plant (Fig. 2, data not shown). Expression of prhA was constitutive (Marenda et al. 1998; unpublished result); hence, we used prhA as a reference gene. Gene expression levels were normalized against the expression level of prhA in RK5134 (Table 4). No difference was observed in the relative expression levels of prhIR (RK5130) in the three culture conditions (Table 4). The relative expression levels of prhJ (RK5124) and hrpG (RK5120) were slightly lower in nutrient-poor medium than in nutrient-rich medium or the co-cultivation with A. thaliana seedlings (Table 4). The expression level of hrpB (RK5046) was 10 times higher in nutrient-poor medium than in nutrient-rich medium, as demonstrated previously (Arlat et al. 1992; Genin et al. 1992), and was increased even more in the co-cultivation with A. thaliana seedlings, as demonstrated previously (Marenda et al. 1998).
Virulence of hrpGD51N mutant on tobacco. Tobacco (Nicotiana benthamiana) plants, 4 weeks old, were inoculated by leaf infiltration with 50 μl of a 108 cells/ml suspension and monitored daily for disease development. Plants were rated on a disease index scale as follows: 0 (no wilting), 1 (1–25% wilting), 2 (>25–50% wilting), 3 (>50–75% wilting), and 4 (>75–100% wilting or dead). Wild type OE1-1 (circles), hrpG mutant RK5120 (triangles), and hrpGD51N mutant RK5240 (squares). Points are the average of three separate experiments containing at least nine plants. Bars indicate standard errors
Effect of PrhA on the expression of genes in the regulatory cascade
Expression of prhJ and hrpG is reduced in the prhA mutant background during co-cultivation with Arabidopsis cell suspensions (Brito et al. 1999). We re-examined the influence of PrhA on the expression of the regulatory cascade genes in three different culture conditions. The expression of prhIR in the ΔprhA background was the same as in the wild type in all three conditions (Table 4, RK5218 vs. RK5130). This result was expected because PrhR is thought to interact with PrhA (Brito et al. 2002), which is not supposed to regulate transcription of prhR. The expression levels of both prhJ and hrpG were reduced in the ΔprhA background in all three conditions, although the extent of reduction differed between culture conditions and genes (Table 4, RK5224 vs. RK5124 and RK5220 vs. RK5120). From these results, we conclude that PrhA is necessary for full expression of prhJ and hrpG regardless of the culture condition in which R. solanacearum cells grow.
Involvement of HrpG phosphorylation in hrpB induction and virulence
Although hrpG was highly expressed in all three culture conditions, the induction level of hrpB differed significantly depending on the culture conditions. We speculated that HrpG must be modified posttranslationally in nutrient-poor medium and with co-cultivation with A. thaliana seedlings. Because HrpG is annotated as a response regulator of two-component signal transduction systems, HrpG could be phosphorylated posttranslationally. A conserved phosphorylation site D51 was identified on the basis of the amino acid alignment of several response regulators (Brito et al. 1999). We mutated the D51 residue in HrpG to Asn and examined the influence on hrpB expression. While the hrpG null mutation in RK5198 reduced hrpB expression to the basal level, the expression of hrpB greatly decreased but was not completely abolished in hrpGD51N mutant RK5243 when co-cultivation with A. thaliana seedlings or in nutrient-poor medium (Table 5). The expression of popA decreased to the same extent as hrpB in the hrpGD51N mutant (data not shown).
Leaves of N. benthamiana plants were inoculated with wild-type OE1-1, hrpGD51N mutant RK5240, and hrpG null mutant RK5120. No disease symptoms were observed in RK5120-infiltrated plants (Fig. 2). Necrotic lesions were observed at 2 days post-inoculation (dpi) on the leaves infiltrated with OE1-1, and the plants wilted within 10 days (Fig. 2). On the other hand, RK5240-infiltrated leaves had necrotic lesions at 3–4 dpi; the plants started to wilt at 9 dpi and wilted much more slowly than OE1-1-infiltrated plants (Fig. 2), indicating that the mutation of the phosphorylation site in hrpG severely reduces the virulence of R. solanacearum.
Discussion
HrpB is the factor that directly regulates the hrp regulon. When hrpB is constitutively expressed from a strong promoter, the hrp regulon is induced even in nutrient-rich medium (Tamura et al. 2005). HrpG is the upstream regulator of HrpB in the complex regulatory cascade. In this study, we clearly demonstrated that the aspartate residue at the predicted phosphorylation site of HrpG (D51) was important for HrpG function. HrpG belongs to a family of response regulators of two-component signal transduction systems (Salanoubat et al. 2002). We speculate that a new signal cascade activates the HrpG protein by phosphorylation. HrpG proteins in Xanthomonas and R. solanacearum share more than 40% amino acid identity. The importance of HrpG phosphorylation has been suggested for X. campestris pv. vesicatoria (Wengelnik et al. 1996, 1999). We have measured the expression levels of prhA, prhIR, prhJ, and hrpG and monitored hrpB expression in different culture conditions. Taking these results together, we can summarize the patterns of signal integration by HrpG in different culture conditions (Fig. 3). On the basis of this model, two distinct signal cascades are involved in HrpG activation and, in turn, the induction of hrpB expression. The first cascade is the well-known, complex regulatory cascade composed of PrhA–PrhR/PrhI–PrhJ–HrpG (Brito et al. 2002). Signals are recognized by PrhA and finally trigger induction of hrpG expression. This cascade controls hrpG transcription. The newly demonstrated second cascade starts from an unidentified receptor, goes through a two-component signal transduction pathway, and finally activates HrpG. The second cascade is involved in posttranslational modification of HrpG, presumably by phosphorylation. While we have no answer to the question of why R. solanacearum uses such a complex system, both cascades are necessary for the formation of active HrpG and hrpB induction.
Proposed models for the two signal cascades for HrpG activation in Ralstonia solanacearum cells cultivated in a nutrient-rich medium, b nutrient-poor medium, or c co-cultivated with A. thaliana seedlings. The left half represents the complex multigene regulatory cascade, and the right half shows the new cascade including the two-component system. OM and IM represent outer and inner membranes. Gene names are given on the thin lines. Dashed lines show transcription/translation. Boxed letters represent proteins. Thick boxed lines indicate a higher expression level. Shaded boxes show the phosphorylated HrpG
Both prhA and prhIR were constitutively expressed in all conditions. In the nutrient-rich medium, where R. solanacearum cells have no physical contact with plant cells, prhJ and hrpG were expressed in a PrhA-dependent manner via the multigene regulatory cascade (Fig. 3a). On the other hand, the second cascade was not active because there were no plant signals. As a result, HrpG remained inactive, and hrpB expression was not induced. In the nutrient-poor medium, the expression of prhJ and hrpG seemed to be at a basal level (Table 4). Even though the expression level of hrpG was slightly lower in the nutrient-poor medium than in the nutrient-rich medium, HrpG could induce hrpB expression at a much higher level because HrpG was activated through the new signal cascade (Fig. 3b). The metabolic signal in the nutrient-poor medium could be sensed by the new signal cascade and activate HrpG. When the bacteria was co-cultivated with A. thaliana seedlings, prhJ and hrpG were expressed through the first cascade. Expressed HrpG was fully activated by the second cascade and induced a higher level of hrpB expression (Fig. 3c).
R. solanacearum cells sense several signals to induce hrpB expression and the hrp regulon. A nondiffusible signal present in the plant cell wall was identified as the factor that induced a hrpB–gfp reporter gene (Aldon et al. 2000). Although this signal is thought to be recognized by PrhA, the signal could instead be used by the second cascade (Fig. 3c) because the complex regulatory cascade composed of PrhA–PrhR/PrhI–PrhJ–HrpG was activated in the absence of plant signals (Table 4), and the activation of both cascades by signal recognition is needed for hrpB induction. PrhA belongs to the TonB-dependent siderophore-receptor proteins, which are located in the outer membrane (Marenda et al. 1998). Siderophore-receptor proteins bind specific iron-siderophore complexes and transport iron into the periplasm. Although PrhA is not related to iron transport (Marenda et al. 1998), PrhA might bind compounds that resemble siderophores, such as nonribosomal peptides (Neilands 1995).
HrpG integrates the PhcA-dependent quorum sensing signal (Genin et al. 2005). Recently, we reported that PhcA binds to the promoter region of prhIR and represses prhIR expression (Yoshimochi et al. 2009). At high cell density, active PhcA represses prhIR expression, and hrpG expression is dramatically reduced because the complex signal cascade is not working. We observed that at high cell density hrpB expression was reduced even in the co-cultivation with A. thaliana seedlings (unpublished data). In this situation, the first cascade may be inactive while the newly demonstrated second cascade is active.
The hrpG null mutant completely lost pathogenicity (Fig. 2) (Brito et al. 1999). In contrast, although the hrpGD51N mutant had reduced pathogenicity on tobacco, it was still able to cause disease. Concomitantly, HrpGD51N could induce hrpB expression, although at a low level. HrpG is a member of the OmpR/PhoB subfamily of response regulator transcription factors with a C-terminal winged helix-turn-helix DNA-binding motif (Toro-Roman et al. 2005); members of this subfamily are known to bind as tandem dimers to DNA direct repeat recognition sequences. The OmpR/PhoB family has a common dimerization mechanism mediated by the α4–β5–α5 interface (Toro-Roman et al. 2005). Phosphorylation induces a conformational change in the α4–β5–α5 face that in turn promotes dimerization. It is well known that dimerization allows or increases DNA binding to the promoter recognition element (Simonovic and Volz 2001). The α4–β5–α5 interface contains 11 well-conserved amino acid residues (Toro-Roman et al. 2005). HrpG has three residue substitutions, which could affect its interactions at the dimer interface. Nonphosphorylated HrpG might form dimers at low efficiency and bind to the hrpB promoter, resulting in weak expression of hrpB. The hrpB expression of RK5046 (wild type hrpG) grown in nutrient-rich medium (Table 4) was similar to that of RK5243 (hrpGD51N) grown with A. thaliana seedlings (Table 5). In both conditions, hrpG is expressed, but HrpG might not be phosphorylated (Fig. 3a, c). When hrpG was supplied in trans from a multicopy plasmid in RK5198 (ΔhrpG), hrpB expression was highly induced even in nutrient-rich medium (unpublished data), also in support of the idea that nonphosphorylated HrpG can bind to the hrpB promoter. HrpG is known to regulate the expression of several virulence genes other than hrpB (Valls et al. 2006). Nonphosphorylated HrpG could activate some of these virulence genes.
More than 40 sensor kinases of two-component systems have been annotated in R. solanacearum GMI1000 (Cunnac et al. 2004). HrpG is an orphan, and no cognate kinase genes have been identified. By using a yeast two-hybrid system, HrpG of X. axonopodis pv. citri was found to interact with a single prey derived from the XAC3683 gene that encodes a composite sensor-histidine kinase/response regulator (Alegria et al. 2004). We have identified a homologous gene rsp1676 encoding a composite two-component regulatory protein on the megaplasmid of R. solanacearum GMI1000 (Salanoubat et al. 2002). XAC3683 shows 32% identity in amino acids to RSp1676. This composite kinase could be a candidate for the cognate kinase that phosphorylates HrpG. We are planning to test phosphotransfer activity from RSp1676 to HrpG to confirm that RSp1676 could be a counterpart of HrpG.
References
Aldon D, Brito B, Boucher C, Genin S (2000) A bacterial sensor of plant cell contact controls the transcriptional induction of Ralstonia solanacearum pathogenicity genes. EMBO J 19:2304–2314
Alegria MC, Docena C, Khater L, Ramos CHI, da Silva ACR, Farah CS (2004) New protein–protein interactions identified for the regulatory and structural components and substrates of the type III secretion system of the phytopathogen Xanthomonas axonopodis pathovar citri. J Bacteriol 186:6186–6197
Arlat M, Gough CL, Zischek C, Barberis PA, Trigalet A, Boucher CA (1992) Transcriptional organization and expression of the large hrp gene cluster of Pseudomonas solanacearum. Mol Plant Microbe Interact 5:187–193
Arlat M, Van Gijsegem F, Huet JC, Pernollet JC, Boucher CA (1994) PopA1, a protein which induces a hypersensitivity-like response on specific Petunia genotypes, is secreted via the Hrp pathway of Pseudomonas solanacearum. EMBO J 13:543–553
Arnold DL, Pitman A, Jackson RW (2003) Pathogenicity and other genomic islands in plant pathogenic bacteria. Mol Plant Pathol 4:407–420
Boucher CA, Barberis PA, Trigalet AP, Demery DA (1985) Transposon mutagenesis of Pseudomonas solanacearum: Isolation of Tn5-induced avirulent mutants. J Gen Microbiol 131:2449–2457
Brito B, Marenda M, Barberis P, Boucher C, Genin S (1999) prhJ and hrpG, two new components of the plant signal-dependent regulatory cascade controlled by PrhA in Ralstonia solanacearum. Mol Microbiol 31:237–251
Brito B, Aldon D, Barberis P, Boucher C, Genin S (2002) A signal transfer system through three compartments transduces the plant cell contact-dependent signal controlling Ralstonia solanacearum hrp genes. Mol Plant Microbe Interact 15:109–119
Brumbley SM, Carney BF, Denny TP (1993) Phenotype conversion in Pseudomonas solanacearum due to spontaneous inactivation of PhcA, a putative LysR transcriptional regulator. J Bacteriol 175:5477–5487
Clough SJ, Flavier AB, Schell MA, Denny TP (1997) Differential expression of virulence genes and motility in Ralstonia (Pseudomonas) solanacearum during exponential growth. Appl Environ Microbiol 63:844–850
Cunnac S, Boucher C, Genin S (2004) Characterization of the cis-acting regulatory element controlling HrpB-mediated activation of the type III secretion system and effector genes in Ralstonia solanacearum. J Bacteriol 186:2309–2318
Fujiwara T, Hirai MY, Chino M, Komeda Y, Naito S (1992) Effects of sulfur nutrition on expression of the soybean seed storage protein genes in transgenic Petunia. Plant Physiol 99:263–268
Galán JE, Collmer A (1999) Type III secretion machines: bacterial devices for protein delivery into host cells. Science 284:1322–1328
Genin S, Gough CL, Zischek C, Boucher CA (1992) Evidence that the hrpB gene encodes a positive regulator of pathogenicity genes from Pseudomonas solanacearum. Mol Microbiol 6:3065–3076
Genin S, Brito B, Denny TP, Boucher C (2005) Control of the Ralstonia solanacearum Type III secretion system (Hrp) genes by the global virulence regulator PhcA. FEBS Lett 579:2077–2081
Hueck CJ (1998) Type III protein secretion systems in bacterial pathogens of animals and plants. Microbiol Mol Biol Rev 62:379–433
Kanda A, Ohnishi S, Tomiyama H, Hasegawa H, Yasukohchi M, Kiba A, Ohnishi K, Okuno T, Hikichi Y (2003a) Type III-secretion machinery-deficient mutants of Ralstonia solanacearum lose their ability to colonize resulting in loss of pathogenicity. J Gen Plant Pathol 69:250–257
Kanda A, Yasukohchi M, Ohnishi K, Kiba A, Okuno T, Hikichi Y (2003b) Ectopic expression of Ralstonia solanacearum effector protein PopA early in invasion results in loss of virulence. Mol Plant Microbe Interact 16:447–455
Marenda M, Brito B, Callard D, Genin S, Barberis P, Boucher C, Arlat M (1998) PrhA controls a novel regulatory pathway required for the specific induction of Ralstonia solanacearum hrp genes in the presence of plant cells. Mol Microbiol 27:437–453
Miller JH (1992) The lac system. In: Miller JH (ed) A short course in bacterial genetics. A laboratory manual and handbook for Escherichia coli and related bacteria. Cold Spring Harbor Laboratory Press, Plainview, pp 43–80
Mukaihara T, Tamura N, Murata Y, Iwabuchi M (2004) Genetic screening of Hrp type III-related pathogenicity genes controlled by the HrpB transcriptional activator in Ralstonia solanacearum. Mol Microbiol 54:863–875
Neilands JB (1995) Siderophores: structure and function of microbial iron transport compounds. J Biol Chem 270:26723–26726
Salanoubat M, Genin S, Artiguenave F, Gouzy J, Mangenot S, Arlat M, Billault A, Brottier P, Camus JC, Cattolico L, Chandler M, Choisne N, Claudel-Renard C, Cunnac S, Demange N, Gaspin C, Lavie M, Moisan A, Robert C, Saurin W, Schiex T, Siguier P, Thébault P, Whalen M, Wincker P, Levy M, Weissenbach J, Boucher CA (2002) Genome sequence of the plant pathogen Ralstonia solanacearum. Nature 415:497–502
Schäfer A, Tauch A, Jäger W, Kalinowski J, Thierbach G, Pühler A (1994) Small mobilizable multi-purpose cloning vectors derived from the Escherichia coli plasmids pK18 and pK19: selection of defined deletions in the chromosome of Corynebacterium glutamicum. Gene 145:69–73
Schell MA (2000) Control of virulence and pathogenicity genes of Ralstonia solanacearum by an elaborate sensory network. Annu Rev Phytopathol 38:263–292
Simon R, Priefer U, Pühler A (1983) A broad host range mobilization system for in vivo genetic engineering: transposon mutagenesis in gram negative bacteria. Bio/Technology 1:784–791
Simonovic M, Volz K (2001) A distinct meta-active conformation in the 1.1-Å resolution structure of wild-type ApoCheY. J Biol Chem 276:28637–28640
Tamura N, Murata Y, Mukaihara T (2005) Isolation of Ralstonia solanacearum hrpB constitutive mutants and secretion analysis of hrpB-regulated gene products that share homology with known type III effectors and enzymes. Microbiology 151:2873–2884
Toro-Roman A, Mack TR, Stock AM (2005) Structural analysis and solution studies of the activated regulatory domain of the response regulator ArcA: a symmetric dimer mediated by the α4–β5–α5 face. J Mol Biol 349:11–26
Valls M, Genin S, Boucher C (2006) Integrated regulation of the type III secretion system and other virulence determinants in Ralstonia solanacearum. PLoS Pathog 2:e82
Van Gijsegem F, Gough C, Zischek C, Niqueux E, Arlat M, Genin S, Barberis P, German S, Castello P, Boucher C (1995) The hrp gene locus of Pseudomonas solanacearum, which controls the production of a type III secretion system, encodes eight proteins related to components of the bacterial flagellar biogenesis complex. Mol Microbiol 15:1095–1114
Wengelnik K, Van den Ackerveken G, Bonas U (1996) HrpG, a key hrp regulatory protein of Xanthomonas campestris pv. vesicatoria is homologous to two-component response regulators. Mol Plant Microbe Interact 9:704–712
Wengelnik K, Rossier O, Bonas U (1999) Mutations in the regulatory gene hrpG of Xanthomonas campestris pv. vesicatoria result in constitutive expression of all hrp genes. J Bacteriol 181:6828–6831
Yoshimochi T, Hikichi Y, Kiba A, Ohnishi K (2009) The global virulence regulator PhcA negatively controls the Ralstonia solanacearum hrp regulatory cascade by repressing expression of the PrhIR signalling proteins. J Bacteriol. doi:10.1128/JB.01113-08
Acknowledgments
This work was supported in part by KAKENHI (Grant-in-Aid for Scientific Research) from Japan Society for the Promotion of Science (16658020 to Y.H. and 17380031 to K.O.).
Author information
Authors and Affiliations
Corresponding author
Rights and permissions
About this article
Cite this article
Yoshimochi, T., Zhang, Y., Kiba, A. et al. Expression of hrpG and activation of response regulator HrpG are controlled by distinct signal cascades in Ralstonia solanacearum . J Gen Plant Pathol 75, 196–204 (2009). https://doi.org/10.1007/s10327-009-0157-1
Received:
Accepted:
Published:
Issue Date:
DOI: https://doi.org/10.1007/s10327-009-0157-1